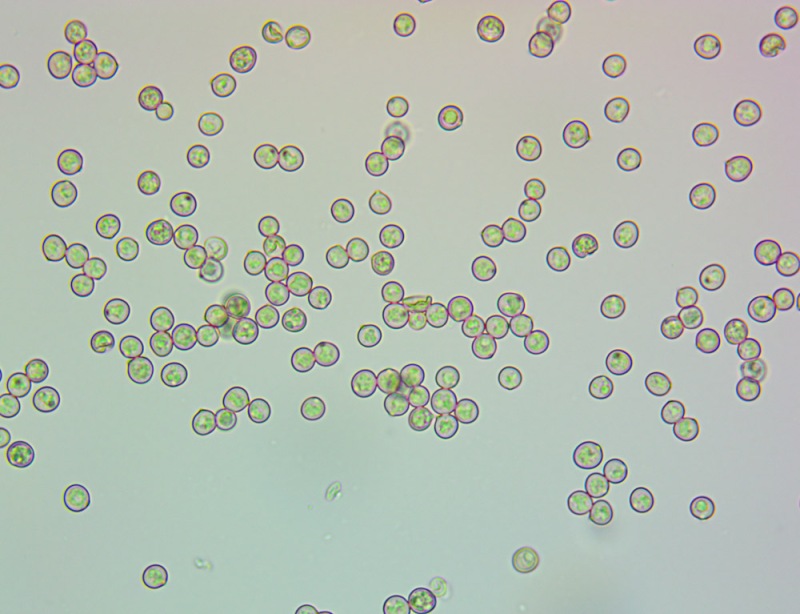

-
Numero contenuti
739 -
Iscritto
-
Ultima visita
Tipo di contenuto
Profili
Forum
Orchidee
Diventa Socio
Calendario
Tutti i contenuti di Antonio Albanese
-

2022.11 - Trentino-Alto Adige - Tutor Pietro Curti
Antonio Albanese ha risposto alla discussione di Pietro Curti in Funghi Trovati Anno 2022
Tolypocladium capitatum (Holmsk.) Quandt, Kepler & Spatafora; Regione Trentino-Alto Adige; Novembre 2022; Foto di Antonio Albanese. Asco. Osservazione in rosso Congo, a 100×. -

2022.11 - Trentino-Alto Adige - Tutor Pietro Curti
Antonio Albanese ha risposto alla discussione di Pietro Curti in Funghi Trovati Anno 2022
Tolypocladium capitatum (Holmsk.) Quandt, Kepler & Spatafora; Regione Trentino-Alto Adige; Novembre 2022; Foto di Antonio Albanese. Asco. Osservazione in rosso Congo, a 400×. -

2022.11 - Trentino-Alto Adige - Tutor Pietro Curti
Antonio Albanese ha risposto alla discussione di Pietro Curti in Funghi Trovati Anno 2022
Tolypocladium capitatum (Holmsk.) Quandt, Kepler & Spatafora; Regione Trentino-Alto Adige; Novembre 2022; Foto di Antonio Albanese. Periteci. Osservazione in acqua, a 100×. -

2022.11 - Trentino-Alto Adige - Tutor Pietro Curti
Antonio Albanese ha risposto alla discussione di Pietro Curti in Funghi Trovati Anno 2022
Tolypocladium capitatum (Holmsk.) Quandt, Kepler & Spatafora; Regione Trentino-Alto Adige; Novembre 2022; Foto di Antonio Albanese. Periteci. Osservazione in rosso Congo, a 100×. -

2022.11 - Trentino-Alto Adige - Tutor Pietro Curti
Antonio Albanese ha risposto alla discussione di Pietro Curti in Funghi Trovati Anno 2022
Tolypocladium capitatum (Holmsk.) Quandt, Kepler & Spatafora; Regione Trentino-Alto Adige; Novembre 2022; Foto di Antonio Albanese. Periteci. Osservazione in rosso Congo, a 100×. -

2022.11 - Trentino-Alto Adige - Tutor Pietro Curti
Antonio Albanese ha risposto alla discussione di Pietro Curti in Funghi Trovati Anno 2022
Tolypocladium capitatum (Holmsk.) Quandt, Kepler & Spatafora; Regione Trentino-Alto Adige; Novembre 2022; Foto di Antonio Albanese. Particolare macro dei periteci. -

2022.11 - Trentino-Alto Adige - Tutor Pietro Curti
Antonio Albanese ha risposto alla discussione di Pietro Curti in Funghi Trovati Anno 2022
Tolypocladium capitatum (Holmsk.) Quandt, Kepler & Spatafora; Regione Trentino-Alto Adige; Novembre 2022; Foto di Antonio Albanese. Particolare della sezione. -

2022.11 - Trentino-Alto Adige - Tutor Pietro Curti
Antonio Albanese ha risposto alla discussione di Pietro Curti in Funghi Trovati Anno 2022
Elaphomyces granulatus Fr. : Fr.; Regione Trentino-Alto Adige; Novembre 2022; Foto di Antonio Albanese. Spore. Osservazione in rosso Congo, a 630×. -

2022.11 - Trentino-Alto Adige - Tutor Pietro Curti
Antonio Albanese ha risposto alla discussione di Pietro Curti in Funghi Trovati Anno 2022
Elaphomyces granulatus Fr. : Fr.; Regione Trentino-Alto Adige; Novembre 2022; Foto di Antonio Albanese. Particolare della sezione. -

2022.11 - Trentino-Alto Adige - Tutor Pietro Curti
Antonio Albanese ha risposto alla discussione di Pietro Curti in Funghi Trovati Anno 2022
Elaphomyces granulatus Fr. : Fr. parassitata da Tolypocladium capitatum (Holmsk.) Quandt, Kepler & Spatafora; Regione Trentino-Alto Adige; Novembre 2022; Foto di Antonio Albanese. -

2022.09 - Trentino-Alto Adige - Tutor Pietro Curti
Antonio Albanese ha risposto alla discussione di Pietro Curti in Funghi Trovati Anno 2022
Galerina marginata (Batsch) Kühner; Regione Trentino-Alto Adige; Settembre 2022; Foto di Antonio Albanese. -

2022.09 - Trentino-Alto Adige - Tutor Pietro Curti
Antonio Albanese ha risposto alla discussione di Pietro Curti in Funghi Trovati Anno 2022
Galerina marginata (Batsch) Kühner; Regione Trentino-Alto Adige; Settembre 2022; Foto di Antonio Albanese. -

2022.10 - Lazio - Tutor Tomaso Lezzi
Antonio Albanese ha risposto alla discussione di Tomaso Lezzi in Funghi Trovati Anno 2022
-

2022.10 - Lazio - Tutor Tomaso Lezzi
Antonio Albanese ha risposto alla discussione di Tomaso Lezzi in Funghi Trovati Anno 2022
-

2022.10 - Lazio - Tutor Tomaso Lezzi
Antonio Albanese ha risposto alla discussione di Tomaso Lezzi in Funghi Trovati Anno 2022
Pluteus romellii (Britzelm.) Sacc.; Regione Lazio; Ottobre 2022; Foto di Antonio Albanese. Pleurocistidi. Osservazione in rosso Congo, contrasto di fase, a 630×. -

2022.10 - Lazio - Tutor Tomaso Lezzi
Antonio Albanese ha risposto alla discussione di Tomaso Lezzi in Funghi Trovati Anno 2022
Pluteus romellii (Britzelm.) Sacc.; Regione Lazio; Ottobre 2022; Foto di Antonio Albanese. Pleurocistidio. Osservazione in rosso Congo, contrasto di fase, a 630×. -

2022.10 - Lazio - Tutor Tomaso Lezzi
Antonio Albanese ha risposto alla discussione di Tomaso Lezzi in Funghi Trovati Anno 2022
Pluteus romellii (Britzelm.) Sacc.; Regione Lazio; Ottobre 2022; Foto di Antonio Albanese. Pleurocistidi utriformi. Osservazione in rosso Congo, a 630×. -

2022.10 - Lazio - Tutor Tomaso Lezzi
Antonio Albanese ha risposto alla discussione di Tomaso Lezzi in Funghi Trovati Anno 2022
Pluteus romellii (Britzelm.) Sacc.; Regione Lazio; Ottobre 2022; Foto di Antonio Albanese. Spore (5,1) 5,5 - 6,3 (7) × (4,7) 5,2 - 6,1 (6,5) µm; Q = 1 - 1,07 (1,1); N = 27; Me = 5,9 × 5,7 µm; Qe = 1; globose, ialine, lisce, monoguttulate. Osservazione in acqua, a 630×. -

2022.10 - Lazio - Tutor Tomaso Lezzi
Antonio Albanese ha risposto alla discussione di Tomaso Lezzi in Funghi Trovati Anno 2022
Pluteus romellii (Britzelm.) Sacc.; Regione Lazio; Ottobre 2022; Foto di Antonio Albanese. Cheilocistidi. Osservazione in rosso Congo, contrasto di fase, a 400×. -

2022.10 - Lazio - Tutor Tomaso Lezzi
Antonio Albanese ha risposto alla discussione di Tomaso Lezzi in Funghi Trovati Anno 2022
Pluteus romellii (Britzelm.) Sacc.; Regione Lazio; Ottobre 2022; Foto di Antonio Albanese. Cheilocistidio. -

2022.10 - Lazio - Tutor Tomaso Lezzi
Antonio Albanese ha risposto alla discussione di Tomaso Lezzi in Funghi Trovati Anno 2022
Pluteus romellii (Britzelm.) Sacc.; Regione Lazio; Ottobre 2022; Foto di Antonio Albanese. Cheilocistidi piriformi. Osservazione in rosso Congo, a 630×. -

2022.10 - Lazio - Tutor Tomaso Lezzi
Antonio Albanese ha risposto alla discussione di Tomaso Lezzi in Funghi Trovati Anno 2022
Pluteus romellii (Britzelm.) Sacc.; Regione Lazio; Ottobre 2022; Foto di Antonio Albanese. Pigmento ocra-brunastro. Osservazione in acqua, a 400×. -

2022.10 - Lazio - Tutor Tomaso Lezzi
Antonio Albanese ha risposto alla discussione di Tomaso Lezzi in Funghi Trovati Anno 2022
Pluteus romellii (Britzelm.) Sacc.; Regione Lazio; Ottobre 2022; Foto di Antonio Albanese. Ife sferopeduncolate della pileipellis. Osservazione in rosso Congo, a 630×. -

2022.10 - Lazio - Tutor Tomaso Lezzi
Antonio Albanese ha risposto alla discussione di Tomaso Lezzi in Funghi Trovati Anno 2022
Pluteus romellii (Britzelm.) Sacc.; Regione Lazio; Ottobre 2022; Foto di Antonio Albanese. Pileipellis. Osservazione in rosso Congo, a 400×. -

2022.10 - Lazio - Tutor Tomaso Lezzi
Antonio Albanese ha risposto alla discussione di Tomaso Lezzi in Funghi Trovati Anno 2022
Pluteus romellii (Britzelm.) Sacc.; Regione Lazio; Ottobre 2022; Foto di Antonio Albanese. Suprapellis di tipo imeniderma, costituita da cellule globose sferopeduncolate, subpellis costituita da ife cilindriche settate. Osservazione in rosso Congo, a 400×.


-2.thumb.jpg.1e01fa06013bd8056d395fb76239d4d7.jpg)
-2.thumb.jpg.76320e01f6065a51282f104093eb920b.jpg)
.jpg.eb552b124a6a1d0cced46444018b7aff.jpg)
-2.thumb.jpg.b7f53c01b0b3ceec0d7a84e2d833633b.jpg)
.thumb.jpg.93408a4c9b0ab74cc8027c7287698d39.jpg)
a.thumb.jpg.702e7a9f1ddd83d22903349a3e68e7f0.jpg)
-2.thumb.jpg.5bcd589795f59ecbf3ad8fc442c59102.jpg)
-2.thumb.jpg.976026fef514a463f681f5d580f45596.jpg)
-2.thumb.jpg.0eb876edd876c3bad9a955319fba7b63.jpg)
-2.thumb.jpg.1ae1a281084abecc86b7e0cea307e433.jpg)
.thumb.jpg.f6eea2861800566ddac7d3b632c9dc32.jpg)
.thumb.jpg.7ca6178d1733819d18d4ce5c76038558.jpg)


.thumb.jpg.04e1f26fe65e934f641afdbad9a0fe36.jpg)
.thumb.jpg.60f7bd7eb263b9954c56caaf8e9933b0.jpg)
.thumb.jpg.ac5d7c3e454808944cc0536e935736d9.jpg)
.thumb.jpg.5486625074dff880645af2ad1c6d4948.jpg)
.thumb.jpg.212aa341d5cb30b6e42a16692632b05c.jpg)
.thumb.jpg.2afa206485009bc5c71d2bd1fc810271.jpg)



